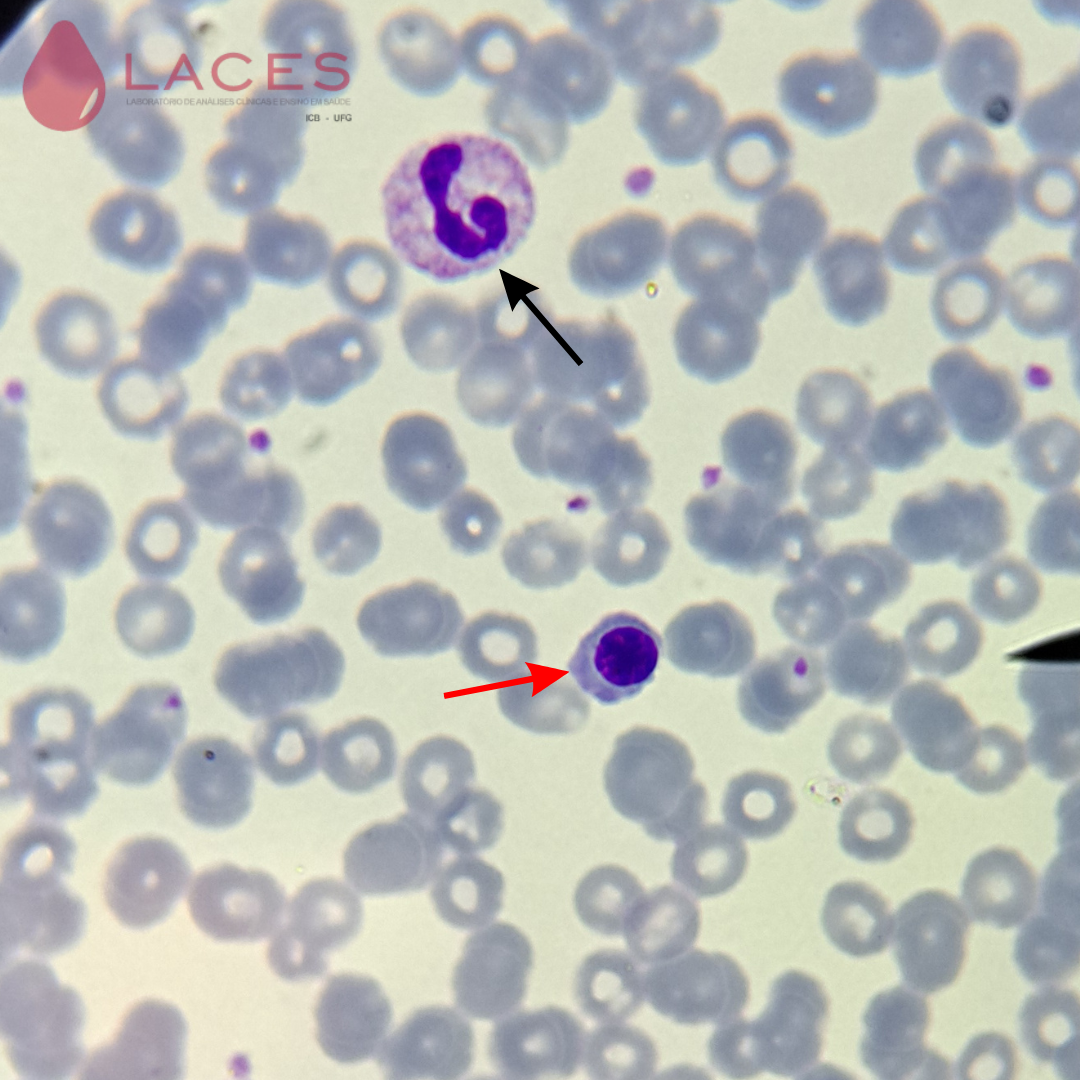
Eritroblasto ortocromático

Eritroblasto Ortocromático
Atualizada em 06/10/25 10:22
O eritroblasto ortocromático é uma célula que possui quase a coloração da hemácia madura. O núcleo é menor e intensamente condensado e intensamente corado de roxo, pode ser central ou excêntrico. O núcleo é uma massa homogênea pronta para ser expulsa.

Figura 1: Eritroblasto ortocromático (seta).

Figura 2: Eritroblasto ortocromático (seta).

Figura 3: Eritroblasto ortocromático (seta).

Figura 4: Eritroblasto ortocromático expelindo núcleo (seta).
Figura 5: Eritroblasto ortocromático (seta vermelha) e neutrófilo segmentado (seta preta).
